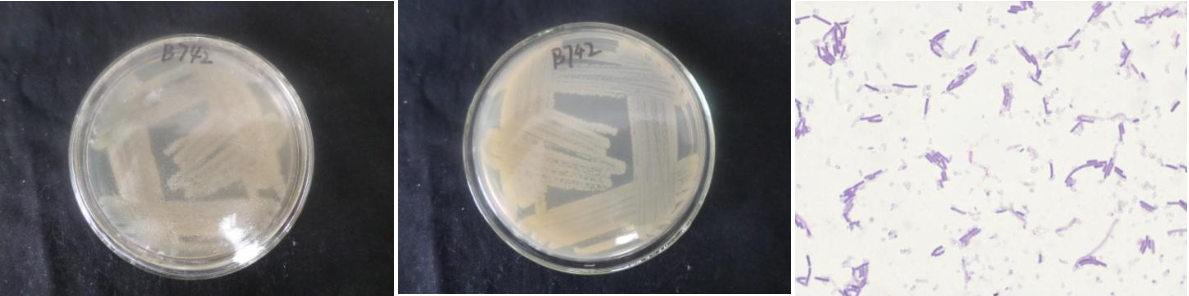

Loading...
| StrainNO | B742 |
| Classification | Kocuria |
| 16s rDNA sequence | GGGGGGGGCGTGCTTACCATGCAAGTCGAACGATGATGCCCAGCTTGCTGGGCGGATTAGTGGCGAACGGGTGAGTAATACGTG AGTAACCTGCCCTTGACTCTGGGATAAGCCTGGGAAACTGGGTCTAATACTGGATACTACCTCTTGCCGCATGGTGGGTGGTGG AAAGGGTTTTACTGGTTTTGGATGGGCTCACGGCCTATCAGCTTGTTGGTGGGGTAATGGCTCACCAAGGCGACGACGGGTAGC CGGCCTGAGAGGGTGACCGGCCACACTGGGACTGAGACACGGCCCAGACTCCTACGGGAGGCAGCAGTGGGGAATATTGCACAA TGGGCGGAAGCCTGATGCAGCGACGCCGCGTGAGGGATGACGGCCTTCGGGTTGTAAACCTCTTTCAGTAGGGAAGAAGCGAGA GTGACGGTACCTGCAGAAGAAGCGCCGGCTAACTACGTGCCAGCAGCCGCGGTAATACGTAGGGCGCAAGCGTTGTCCGGAATT ATTGGGCGTAAAGAGCTCGTAGGCGGTTTGTCGCGTCTGCTGTGAAAGCCCGGGGCTCAACCCCGGGTCTGCAGTGGGTACGGG CAGACTAGAGTGCAGTAGGGGAGACTGGAATTCCTGGTGTAGCGGTGAAATGCGCAGATATCAGGAGGAACACCGATGGCGAAG GCAGGTCTCTGGGCTGTTACTGACGCTGAGGAGCGAAAGCATGGGGAGCGAACAGGATTAGATACCCTGGTAGTCCATGCCGTA AACGTTGGGCACTAGGTGTGGGGGACATTCCACGTTTTCCGCGCCGTAGCTAACGCATTAAGTGCCCCGCCTGGGGAGTACGGC CGCAAGGCTAAAACTCAAAGGAATTGACGGGGGCCCGCACAAGCGGCGGAGCATGCGGATTAATTCGATGCAACGCGAAGAACC TTACCAAGGCTTGACATTCACCGGACCGCCCCAGAGATGGGGTTTCCCTTCGGGGCTGGTGGACAGGTGGTGCATGGTTGTCGT CAGCTCGTGTCGTGAGATGTTGGGTTAAGTCCCGCAACGAGCGCAACCCTCGTTCTATGTTGCCAGCACGTGATGGTGGGGACT CATAGGAGACTGCCGGGGTCAACTCGGAGGAAGGTGGGGATGACGTCAAATCATCATGCCCCTTATGTCTTGGGCTTCACGCAT GCTACAATGGCCGGTACAAAGGGTTGCGATACTGTGAGGTGGAGCTAATCCCAAAAAGCCGGTCTCAGTTCGGATTGAGGTCTG CAACTCGACCTCATGAAGTCGGAGTCGCTAGTAATCGCAGATCAGCAACGCTGCGGTGAATACGTTCCCGGGCCTTGTACACAC CGCCCGTCAAGTCACGAAAGTTGGTAACACCCGAAGCCGGTGGCCTAACCCCTTGTGGGAGGGAGCCGTCGAAGGTGGAACCGG |
| Strain Morphology Photos | |
| Morphological Description | round;clam white;edge serrated;concentric rings;rugose;slippy;sticky;waxy;Rod;having spore with germinal mesophytic |